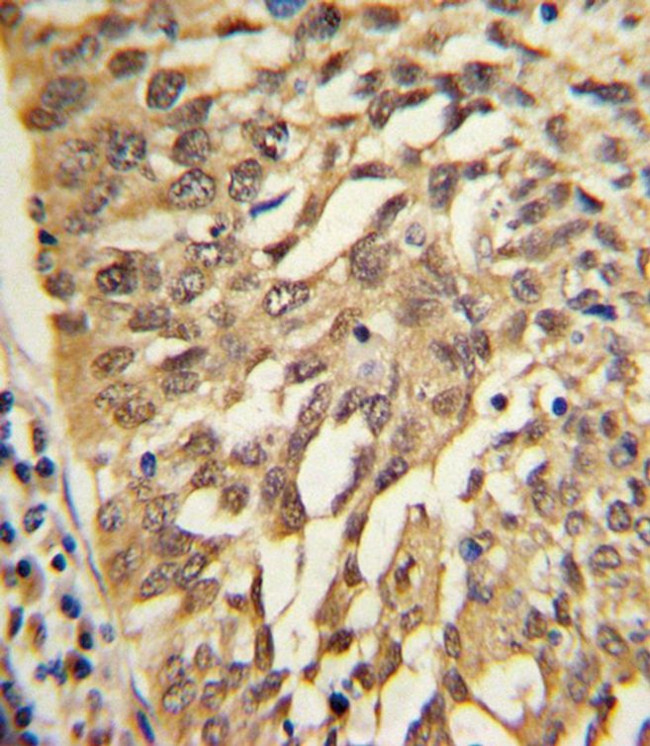
SAR1A Antibody in Immunohistochemistry (IHC)

Search
Invitrogen
SAR1A Polyclonal Antibody
{{$productOrderCtrl.translations['antibody.pdp.commerceCard.promotion.promotions']}}
{{$productOrderCtrl.translations['antibody.pdp.commerceCard.promotion.viewpromo']}}
{{$productOrderCtrl.translations['antibody.pdp.commerceCard.promotion.promocode']}}: {{promo.promoCode}} {{promo.promoTitle}} {{promo.promoDescription}}. {{$productOrderCtrl.translations['antibody.pdp.commerceCard.promotion.learnmore']}}
产品信息
PA5-72494
宿主/亚型
分类
类型
抗原
偶联物
形式
浓度
规格
保存条件
运输条件
RRID
靶标信息
Involved in transport from the endoplasmic reticulum to the Golgi apparatus. Required to maintain SEC16A localization at discrete locations on the ER membrane perhaps by preventing its dissociation. SAR1A-GTP-dependent assembly of SEC16A on the ER membrane forms an organized scaffold defining endoplasmic reticulum exit sites (ERES). [UniProt]
仅用于科研。不用于诊断过程。未经明确授权不得转售。